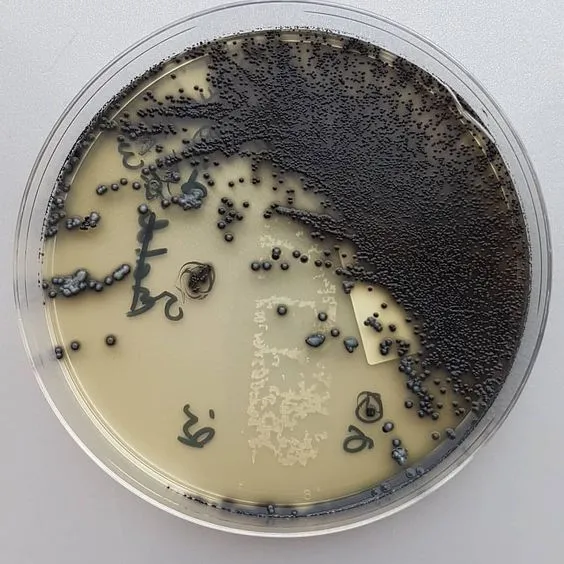
- Corynebacterium diphtheriaein Tinsdale Agar mediumLook for black colonies with brown halo (Image source:  Anonymous)

Tinsdale agar base medium was developed by Tinsdale for the selective isolation and differentiation of C. diphtheriae from diphtheroids. Billings later modified the medium improving its differential qualities and reproducibility.
Moore and Parsons used Billings’ modification and confirmed the appearance of a distinct halo around the colonies of C. ulcerans and C. diphtheriae only. They also found modified Tinsdale medium as satisfactory as cystine-tellurite blood agar for the primary isolation of C. diphtheriae from nose and throat cultures. With these findings, they recommended the use of modified Tinsdale medium for routine isolation of C. diphtheriae.
Composition of modified Tinsdale’s Base medium
pH 7.9 ± 0.2 @ 25°C
| Ingredients | Gm/Liter |
|---|---|
| Peptic digest of animal tissue | 20 g |
| Sodium chloride | 5 g |
| L-Cystine | 0.24 g |
| Sodium thiosulfate | 0.24 g |
| Agar | 15 g |
Tinsdale Supplement (for 1 Liter)
- Sterile bovine serum: 100 mL
- Tellurite solution (1%): 30 mL
Principle
Tinsdale medium supports the growth of all species of Corynebacterium while inhibiting the growth of normal inhabitants of the upper respiratory tract. Potassium tellurite from the supplement inhibits all gram-negative bacteria and most of the upper respiratory tract normal flora.
L-cystine and sodium thiosulphate form the Hâ‚‚S indicator system. Black coloration of the colonies results from tellurite reductase activity, resulting in the reduction of tellurium, while the brown halos indicate cystinase activity. Only C. diphtheriae and C. ulcerans give black colonies with a distinctly outlined halo. Â Â Other diphtheroids, staphylococci, and some streptococci may also reduce tellurite, although halos around the colonies are not generally present.
Peptic digest of animal tissue provides nitrogenous compounds and agar is for the solidification of the medium.
Preparationof Tinsdale Medium
The Tinsdale’s agar base medium without serum and tellurite is stable indefinitely if stored in closed screw-capped tubes or bottles but after the addition of supplement (serum and tellurite), the medium is stable only for 2/3 days if stored in the refrigerator.
Procedure
- Streak the Tinsdale agar plate to obtain well-isolated colonies. Note:It is recommended that the agar be stabbed at intervals because browning of the medium can be detected early (within 10-12 hours incubation) in the stab areas.
- Incubate the plates at 35°C in an aerobic incubator. Note: Growth of Corynebacterium diphtheriae may be inhibited if Tinsdale Agar is incubated in carbon dioxide-enriched air e.g. in aCO2 incubator.
- Examine the colonial morphology after 24 hours and 48 hours of incubation.
Results and Interpretation
A brown halo around the black colony is considered presumptive evidence of C. diphtheriae. This can sometimes be seen after 10–12 hours of incubation, although 48 hours may be required for the appearance of typical dark-brown halos. The only related species other than C. diphtheriae that produces this halo is C. ulcerans.  Isolates with this colonial morphology are first identified biochemically as C. diphtheriae, and subsequent testing involves demonstrating the production of diphtheria toxin.
Other bacteria, such as coagulase-positive staphylococci, grow well on this medium but do not have a brown halo. Bacteria, such as species of Proteusthat produce a heavy, diffuse blackening of the medium, can be distinguished by their Gram stain reaction and biochemical characteristics.
References and further reading
- Moore MS, Parsons EI. A study of modified Tinsdale’s medium for the primary isolation of Corynebacterium diphtheriae. J Infect Dis 1958; 102:88–93.
- Tinsdale GFW. A new medium for the isolation and identification of C. diphtheriae based on the production of hydrogen sulfide. J Pathol Bacteriol 1947; 59:61–66.